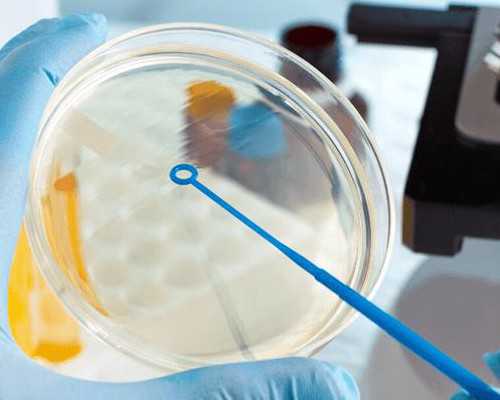
哪里有代怀_试管助孕借卵代怀,医生建议直接做试管婴儿，我还有自然怀孕的可

哪里有代怀_试管助孕借卵代怀,医生建议直接做试管婴儿,我还有自然怀孕的可
发布时间:2024-02-20
发布时间:2024-02-20
在没有实行计划生育后,很多夫妻就想要生二胎,也就能够让孩子有个伴,同时也满足了儿女双全的心愿,不过有些医生却建议做试管婴儿,这到底为什么呢?
二胎什么情况下医生建议做试管婴儿
二胎大多数年龄比较大,想要成功怀孕的几率比较小,很多常见的病症就是排卵障碍、输卵管不通畅,还有就是现在剖腹产的比较多,很容易产生瘢痕,从而就会导致不孕不育的情况,因此女性出现不孕,或者卵巢功能不好的话,男性精子质量不好、数量少,都建议做试管婴儿来怀孕,成功的几率大很多。
不过做试管婴儿的话,就需要夫妻双方去医院做一系列的检查,检查后符合适应症的话,就可以做试管婴儿。另外,试管婴儿过程中要加强营养的补充,多吃蔬菜水果,增加抵抗力,平时还要多锻炼身体,才能有助于成功。
试管婴儿需要哪些证件
试管婴儿做第二胎的话,就需要准生证、身份证、结婚证等,医生会根据提供的证件后,就会安排进行全面的身体检查,身体检查后就根据情况进行评估,评估结果出来后就需要看情况决定治疗方案,然后试管婴儿过程就开始了。
以上就是二胎什么情况下医生建议做试管婴儿,以及做试管婴儿需要哪些证件相关内容,相信大家已经了解了,希望大家能够多去了解,听从医生的建议,才能更好的治疗。
重庆代孕包成功,2026
年重庆供卵试管婴儿医院排名?附医院试管成功率费用明细
有供卵的人 医院给做吗&绝经会怀孕吗,最新2026清宫图生男生女预测表,2026清宫
重庆市妇幼保健院生殖科哪个主管医生做试管好些?
重庆试管婴儿费用是多少?重庆三代试管双胞胎多少钱?
供卵代怀套餐-重庆生殖医院哪里最好
重庆生育政策,对独生子女及二孩三孩家庭都有啥奖励?一文看清楚